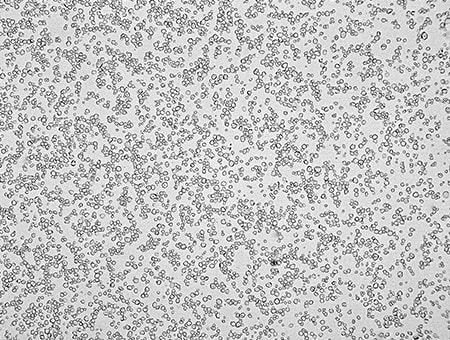

利用影像處理的粒度分布、粒子分析
以往粒徑與粒度分析多以雷射散射式粒徑分析儀或顯微鏡進行分析。近年隨著CMOS拍攝元件與鏡頭精度、照明與影像處理技術提升,逐漸開始使用高性能數位顯微鏡。
最新數位顯微鏡不僅畫質高,更配備各種符合需求的豐富功能,如影像二值化抽出粒子與定量化、重現量測條件等。
在此介紹利用最新的4K數位顯微鏡,解決粒度分布與粒徑分析課題的案例。

何謂利用影像處理的粒度分布、粒子分析
所謂「影像二值化」,是將灰階的影像,轉換成白與黑的處理。設定任意閾值,與各畫素值比較後,大於閾值就轉換成黑,小於閾值則轉換成白。也可指定想二值化的範圍。
影像二值化後,即可針對指定範圍單獨擷取黑色或白色資訊的處理,使粒子分析更簡單快速。


最新的4K數位顯微鏡的粒度分布、粒子分析案例
以往的雷射繞射、散射法*無法針對實際的粒子進行觀察。而用顯微鏡觀察則要求熟練度,難以重現拍攝條件。且資料取得後需使用其他軟體進行分析。
使用4K數位顯微鏡「VHX系列」進行粒度分布與粒子分析,觀察粒子同時,能進行量測。利用影像二值化進行自動面積量測、拍攝設定重現與校正時,不受限於人員的熟練度,簡單操作即可完成。
雷射繞射、散射法
以雷射照射的粒度分布、粒子分析。
利用散射光強度與粒子數量成比例的規則性,及粒子大小與光散射設繞射模式的關聯性的測量分析法。
自動面積量測
在指定範圍內輕鬆進行目標物的面積量測與計數。使用影像亮度和顏色二值化後,能算出面積、最大直徑、最小直徑等參數,並排除不必要的目標物,或將重疊的目標物分離。此外,也可用過去的影像資料,以相同的條件進行分析。
量測值還可輸出為表格、柱狀圖,定量掌握粒度分布的特徵。

拍攝設定重現與校正
以顯微鏡進行觀察時,想重現上次的拍攝條件(照明、快門速度、白平衡等)或二值化時的影像處理及校正等量測條件,都非常困難。
使用4K數位顯微鏡「VHX系列」,從相簿中選擇影像,即可重現過去的拍攝設定。日後不同檢查人員,也可用和上次一樣的拍攝條件進行觀察。



此外,以往須於正確位置上使用對焦尺進行的校正,現在只需設置專用刻度尺後按一下「1 PUSH校正」即可完成。載入照明條件、快門速度、白平衡等鏡頭必要之補正值,電動控制X、Y、Z軸,自動對準位置與焦距。

- A.高解析度HR鏡頭
- B.電動旋轉器

還有許多使粒子分析輕鬆簡單的功能。例如不需更換鏡頭,即可在20~6000倍範圍內自由變更倍率,實現無縫縮放的高解析度HR鏡頭與電動鼻輪等。所有操作都很簡單,即使是不擅長使用的人,也能快速正確的觀察、分析。
觀察、儲存、量測,只要這1台
相較以往的顯微鏡,使用高精細4K數位顯微鏡「VHX系列」可實現高效率化及消除人為誤差的正確量測、分析。
透過光學、影像處理、自動化技術實現的高精細4K影像,簡單操作即可進行粒度分布、粒子分析,可快速取得更高階的分析結果。
拍攝、量測所得資料,除了可經由「報告功能」輕鬆產出報告外,也可在公司內部伺服器共享資料,不僅有助於符合工業規格和品質保證,當發生問題時也可用於找出原因與改善製程。
配備多種功能的「VHX系列」,成為粒度分布與粒子分析的強力夥伴。詳細說明請下載型錄,或洽詢KEYENCE。


